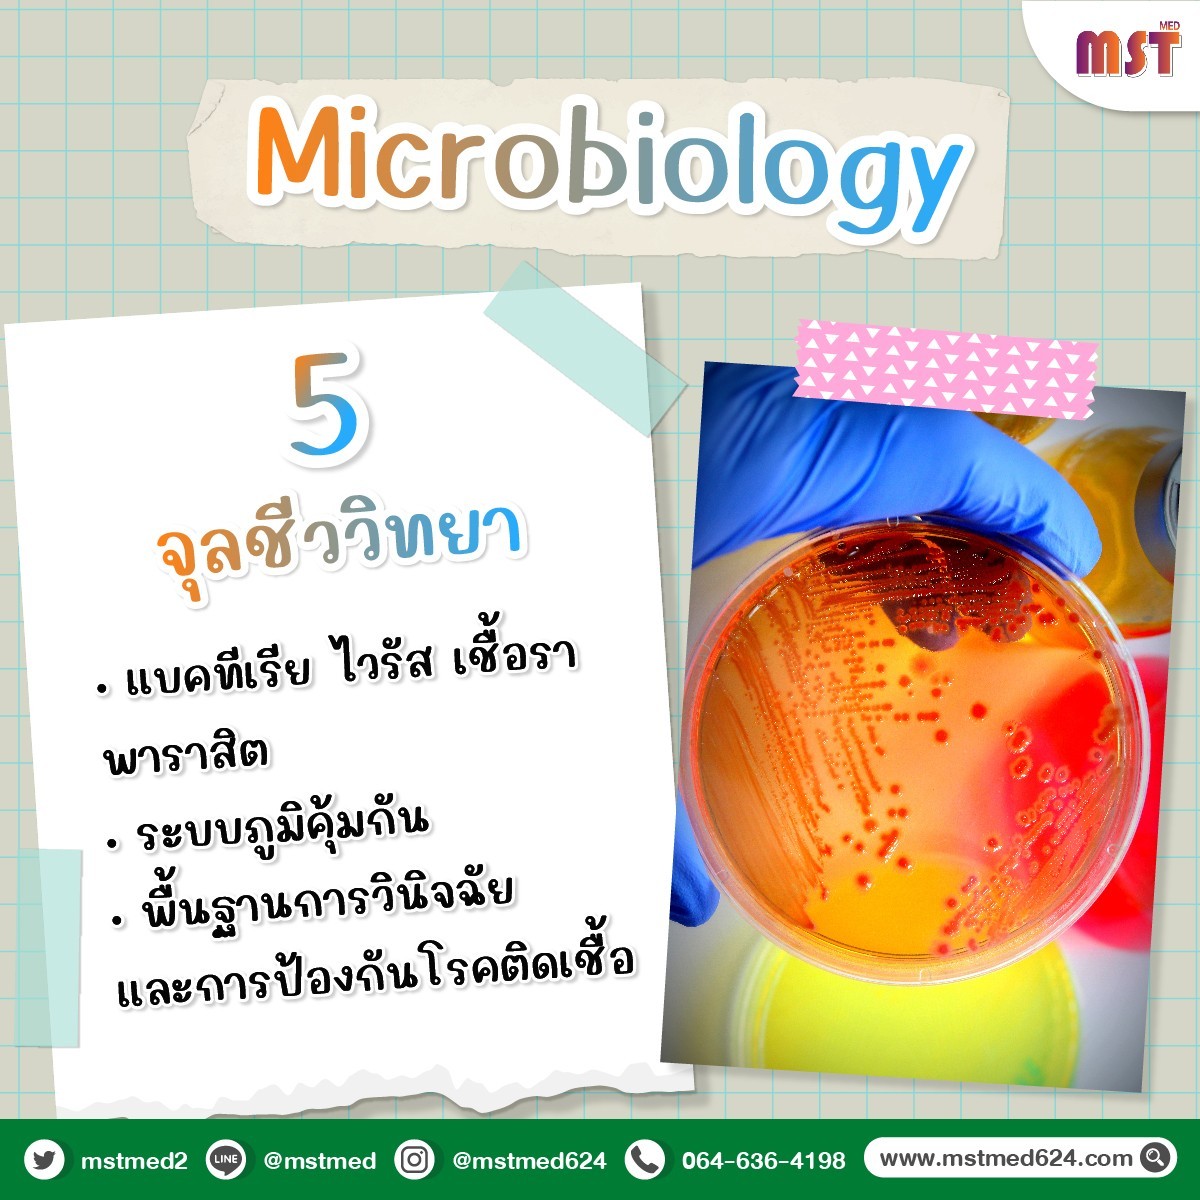

การสอบ NL1 (National License Step 1) ไม่ใช่แค่การสอบธรรมดา แต่มันคือการพิสูจน์ "ฐานราก" ความรู้พรีคลินิกทั้งหมดที่เราเรียนมาตลอด 3 ปี!

เจาะลึก 6 วิชาหลักที่ออกสอบแน่นอน
Anatomy (กายวิภาคศาสตร์) ท่องให้แม่นตั้งแต่โครงสร้าง อวัยวะ ระบบกล้ามเนื้อ ไปจนถึงเส้นประสาทสำคัญๆ
Physiology (สรีรวิทยา) เข้าใจกลไกการทำงานของร่างกาย ระบบหัวใจ ทางเดินหายใจ และการรักษา Homeostasis
Biochemistry (ชีวเคมี) เน้น Metabolism ของสารอาหาร เอนไซม์ วิตามิน และฮอร์โมน (จุดเก็บคะแนนที่ห้ามพลาด!)
Pathology (พยาธิวิทยา) เข้าใจการเปลี่ยนแปลงของเซลล์ กลไกการเกิดโรค และการตอบสนองต่อการบาดเจ็บ
Microbiology (จุลชีววิทยา) รู้จักเชื้อโรคทุกประเภท แบคทีเรีย ไวรัส เชื้อรา ปรสิต และระบบภูมิคุ้มกัน
Pharmacology (เภสัชวิทยา) กลไกการออกฤทธิ์ของยาและผลข้างเคียงที่ต้องระวัง
ลักษณะข้อสอบที่ต้องเตรียมรับมือ
เป็นข้อสอบปรนัย (MCQ) ทั้งหมด ประมาณ 200 ข้อ
ให้เวลาสอบ 4 ชั่วโมง (เฉลี่ยข้อละไม่ถึง 2 นาที!)
เกณฑ์ผ่านคือต้องได้ ≥ 60%
เส้นทางนี้อาจจะเหนื่อย แต่ถ้าเตรียมตัวดี มีชัยไปกว่าครึ่ง! ใครอยากให้สรุปเจาะลึกวิชาไหนเป็นพิเศษ คอมเมนต์บอกกันไว้ได้เลยนะ 
สนใจสมัครสอบถามเพิ่มเติม
ID line :@mstmed (มี @ นำหน้า)
โทร 064-636-4198
YouTube : Mst Med
Facebook : Mst Med ติวเข้าแพทย์ ทันตะ เภสัช ม.รังสิต
: https://www.facebook.com/MSTMED624?locale=th_TH
TikTok : @mstmedwell1
: https://www.tiktok.com/@mstmedwell1?_t=8leANYiYqrx&_r=1
Twitter : @MSTMED2
Ig : mstmedwell
: https://www.instagram.com/mstmedwell/
#NL1 #สอบใบประกอบ #พรีคลินิก #ติวแพทย์ #ติวเข้าแพทย์ #ติวแพทย์รังสิต #ติวทันตะรังสิต #ติวเภสัชรังสิต #แนวข้อสอบหมอ #ข้อสอบแพทย์รังสิต #ข้อสอบทันตะรังสิต #ข้อสอบเภสัชรังสิต #ติวแพทย์รังสิต #ติวทันตะรังสิต #ติวเภสัชรังสิต #ติวสอบหมอรังสิต #ข้อสอบแพทย์รังสิต #ข้อสอบเก่าแพทย์รังสิต #รับตรงแพทย์รังสิต #รับตรงแพทย์รังสิตรอบแรก #กสพท69 #TCAS69

ยังไม่มีความคิดเห็น คุณเป็นคนแรกที่แสดงความเห็น